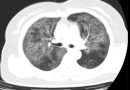
MỘT CA BỆNH HIẾM TẠI KHOA NỘI HÔ HẤP: KHI “TÍCH PROTEIN TRONG PHẾ NANG” LẠI GIÚP TÌM HIỂU LẠI BỆNH PHỔI MÔ KẼ MỘT CA BỆNH HIẾM TẠI KHOA NỘI HÔ HẤP: KHI “TÍCH PROTEIN TRONG PHẾ NANG” LẠI GIÚP TÌM HIỂU LẠI BỆNH PHỔI MÔ KẼ

BỆNH VIỆN C ĐÀ NẴNG NHẬN CHỨNG NHẬN ĐẠT CHUẨN CHẤT LƯỢNG ĐIỀU TRỊ VÀNG (GOLD STATUS AWARD) TỪ HỘI ĐỘT QUỴ THẾ GIỚI
Chiều ngày 05/12/2025, Bệnh viện C Đà Nẵng đã tổ chức thành công Hội thảo “Cập nhật một số điểm mới trong sàng lọc và điều trị bệnh lý đột quỵ não cấp” và Lễ vinh danh Bệnh viện C Đà Nẵng đạt chuẩn chứng nhận vàng (Gold Status Award) trong điều trị Đột quỵ theo các tiêu chí chất lượng của Hội Đột quỵ Thế giới (World Stroke Organization – WSO).